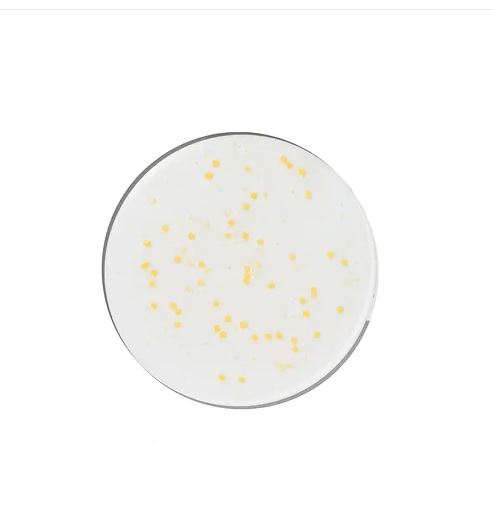

GENABELLE
GENABELLE PDRN Vita Toning Ampoule
GENABELLE PDRN Vita Toning Ampoule
In stock
Unveil your skin’s true radiance with GENABELLE PDRN Vita Toning Ampoule, a lightweight and potent solution designed to brighten and tone your complexion. Enriched with a powerful blend of Vitamin B, C, and E, this ampoule targets stubborn whiteheads, blackheads, blemishes, and breakouts while fortifying your skin barrier. Experience the transformative effects of this innovative formula that hydrates, protects, and soothes your skin from irritation.
What sets GENABELLE PDRN Vita Toning Ampoule apart is its unique combination of Allantoin and Biosaccharide Gum-1, which deeply moisturise and shield your skin, providing lasting comfort and protection. The fresh encapsulated ingredients ensure each application delivers a potent dose of vitamins, resulting in a visibly brighter and more even skin tone. With 5000ppm of PDRN, this ampoule enhances skin elasticity, plumpness, and luminosity, giving you a youthful, radiant glow. Transform your skincare routine with the ultimate vitamin cocktail mix, perfect for reviving dull and rough skin textures.
Size: 30ml
MADE IN KOREA
Ingredients
Ingredients
Note: Ingredients subject to change at manufacturer's discretion. For the most complete and up-to-date list of ingredients, please refer to product packaging.
Water,Butylene Glycol,Niacinamide,Polyglycerin-3,Methylpropanediol,1,2-Hexanediol,Glycereth-26,Glycerin,Mannitol,Sodium DNA,Polyglyceryl-10 Laurate,Microcrystalline Cellulose,Ammonium Acryloyldimethyltaurate/VP Copolymer,Polyacrylate Crosspolymer-6,Acrylates/C10-30 Alkyl Acrylate Crosspolymer,Arginine,Zea Mays (Corn) Starch,Milt Extract,Ethylhexylglycerin,Mica,Allantoin,Caprylyl Glycol,Adenosine,Fragrance,Biosaccharide Gum-1,CI 77492,Sodium Hyaluronate,Tranexamic Acid,Calcium Pantothenate,Maltodextrin,Sodium Starch Octenylsuccinate,Sodium Ascorbyl Phosphate,Tocopheryl Acetate,Pyridoxine HCl,Hydrolyzed Hyaluronic acid,Hydrolyzed Sodium DNA,Hyaluronic Acid,Sodium Acetylated Hyaluronate,Tripeptide-1,Acetyl Hexapeptide-8
How to use
How to use
Apply an appropriate amount onto cleansed and toned skin.
Couldn't load pickup availability
Same day to next day dispatch
Free samples with every order
Gift with purchase on orders over $90
Share